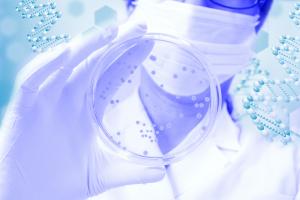
Le microbiote suit aussi son rythme circadien et les bactéries arythmiques annoncent le risque de maladie (Visuel AdobeStock_167581840)

EXERCICE : Pourquoi il fait du bien à certains et à d’autres moins ?
Nous ne sommes pas tous égaux « face » à la pratique de l’exercice et nous n’en tirons pas tous les mêmes bénéfices. C’est la démonstration et l’objet de cette recherche du Beth Israel Deaconess Medical Center (BIDMC) qui décrypte finalement les liens mécanistes entre la forme physique et la santé globale. Ces travaux, publiés dans la revue Nature Metabolism apportent une nouvelle compréhension des effets de l’exercice et éclairent sur les types spécifiques d'exercice les plus bénéfiques à chacun.
« Bien nous bénéficions tous de l'exercice, la variabilité des réponses entre 2 personnes au même programme d’exercice est considérable. Certaines personnes peuvent connaître une amélioration de l'endurance tandis que d'autres vont connaître une amélioration de la glycémie», résume l’auteur principal, le Dr Robert E. Gerszten, chef du Service de médecine cardiovasculaire du BIDMC : « À ce jour, nous ne disposons d’aucun outil diagnostic pour prédire quel type d’exercice est le plus susceptible d’apporter un avantage significatif à une personne donnée ou de répondre à un besoin de santé donné ».
Les protéines produites avec l'exercice diffèrent considérablement d'une personne à l'autre
Des études ont montré que l'exercice stimule la production de composés chimiques circulants qui induisent des effets sur la santé, y compris sur des organes éloignés. L’équipe du BIDMC (Boston) a mesuré les taux sanguins d'environ 5.000 protéines chez 650 adultes sédentaires avant et après un programme d'exercices d'endurance de 20 semaines. Cette analyse complexe révèle que :
- un groupe de 147 protéines dans le sang indique la capacité cardiorespiratoire d'un individu, ou VO2max, au début de l'étude ;
- un autre ensemble de 102 protéines reflète le changement de VO2max après la fin du programme d'exercice ;
- des protéines qui émanent des os, des muscles et des vaisseaux sanguins s’avèrent fortement liées à la forme cardiorespiratoire ;
- en « fin de compte » le chevauchement entre le profil protéique de la VO2max de base et de la VO2max après l'intervention physique est décrit comme « minimal » ;
- les niveaux de base de certaines protéines permettent de prédire la réponse au programme d’exercice (et bien mieux que les résultats de santé généralement pris en compte) ;
- enfin, certaines de ces protéines permettant de prédire la réponse au programme d’exercice, sont également liées à un risque élevé de décès prématuré,
ce qui confirme le lien entre la santé cardiorespiratoire et les résultats de santé à long terme.
Un score protéique pour prédire le changement (ou l’amélioration) de VO2max, c’est ce qu’ont développé les scientifiques de Boston, à l’issue de l’analyse, un score capable d’identifier les personnes capables/incapables d'améliorer significativement leur condition cardiorespiratoire avec un programme d'exercice normalisé. « Nous avons maintenant une méthodologie et une liste détaillée des nouveaux composés sanguins prédicteurs de l'adaptation et de la réponse individuelles à un programme d'exercice.
Le concept d’une « pilule de l’exercice » ? Bien qu'aucune pilule ne puisse jamais rassembler la diversité des avantages de l'exercice, l’étude apporte une feuille de route « protéique » de futures interventions thérapeutiques.
Autres actualités sur le même thème
RISQUE CARDIAQUE : Combiner ApoB au LDL pour un marqueur plus précis
Actualité publiée il y a 3 années 1 moisDIABÈTE : Un test microbiotique pour connaître son risque
Actualité publiée il y a 5 années 9 moisATHÉROSCLÉROSE : La lipoprotéine A, le « meilleur » marqueur de risque ?
Actualité publiée il y a 4 années 1 semaineDIABÈTE, OBÉSITÉ : La protéine qui fait de la mauvaise graisse
Actualité publiée il y a 8 années 11 mois